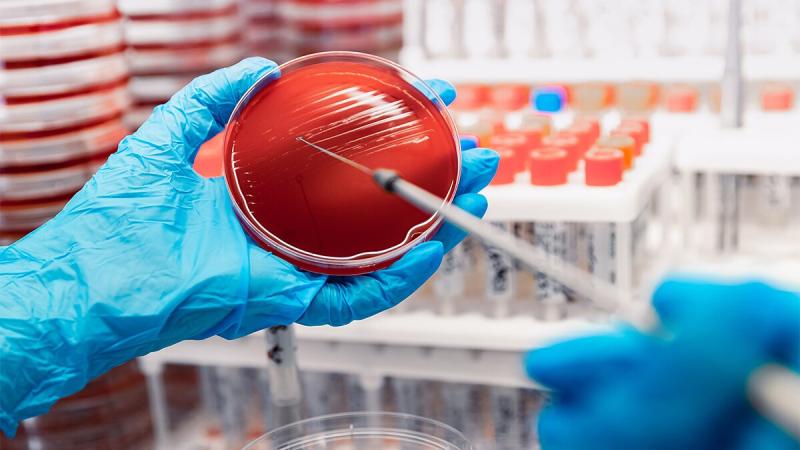

Press release
Molecular Infectious Disease Testing Market Rewriting Long Term Growth Story
The Global Molecular Infectious Disease Testing Market Size is estimated at $10.3 Billion in 2025 and is forecast to register an annual growth rate (CAGR) of 12.8% to reach $30.5 Billion by 2034.The latest study released on the Global Molecular Infectious Disease Testing Market by USD Analytics evaluates market size, trend, and forecast to 2034. The Molecular Infectious Disease Testing market study covers significant research data and proofs to be a handy resource document for managers, analysts, industry experts and other key people to have ready-to-access and self-analyzed study to help understand market trends, growth drivers, opportunities and upcoming challenges and about the competitors.
Key Players in This Report Include:
Abbott, Roche, Thermo Fisher, Bio-Rad, Qiagen, BD, Hologic, BioMérieux, Cepheid, Luminex, Danaher, GenMark Diagnostics
Download Sample Report PDF 👉 https://www.usdanalytics.com/sample-request/32031
Definition:
Diagnostic tests that detect pathogens (viruses, bacteria, etc.) at the molecular level using techniques like PCR to identify genetic material.
Market Drivers:
• Rapid testing, Multiplex assays
Market Trends:
• Disease outbreaks, Precision diagnostics demand
Challenges:
• High equipment costs, regulatory hurdles
Major Highlights of the Molecular Infectious Disease Testing Market report released by USD Analytics
By Products and Services (Reagents & Kits, Instruments, Services & Software), By Type (Multiplex Testing, Singleplex Testing), By Test Type (Laboratory Tests, Point Of Care Tests), By Disease (Respiratory Infectious Diseases, Gastrointestinal Infectious Diseases, Sexually Transmitted Diseases, Hospital-Acquired Infections, Vaginitis, Meningitis, Vector-Borne Diseases, Others), By Technology (Polymerase Chain Reaction, Isothermal Nucleic Acid Amplification Technology, DNA Sequencing & Next-Generation Sequencing, In Situ Hybridization, DNA Microarrays, Others), By End-User (Diagnostic Laboratories, Hospitals & Clinics, Others).
Global Molecular Infectious Disease Testing market report highlights information regarding the current and future industry trends, growth patterns, as well as it offers business strategies to helps the stakeholders in making sound decisions that may help to ensure the profit trajectory over the forecast years.
Buy Complete Assessment of Molecular Infectious Disease Testing Market Now 👉 https://www.usdanalytics.com/payment/report-32031
Geographically, the detailed analysis of consumption, revenue, market share, and growth rate of the following regions:
• The Middle East and Africa (South Africa, Saudi Arabia, UAE, Israel, Egypt, etc.)
• North America (United States, Mexico & Canada)
• South America (Brazil, Venezuela, Argentina, Ecuador, Peru, Colombia, etc.)
• Europe (Turkey, Spain, Turkey, Netherlands Denmark, Belgium, Switzerland, Germany, Russia UK, Italy, France, etc.)
• Asia-Pacific (Taiwan, Hong Kong, Singapore, Vietnam, China, Malaysia, Japan, Philippines, Korea, Thailand, India, Indonesia, and Australia).
Objectives of the Report
• -To carefully analyze and forecast the size of the Molecular Infectious Disease Testing market by value and volume.
• -To estimate the market shares of major segments of the Molecular Infectious Disease Testing market.
• -To showcase the development of the Molecular Infectious Disease Testing market in different parts of the world.
• -To analyze and study micro-markets in terms of their contributions to the Molecular Infectious Disease Testing market, their prospects, and individual growth trends.
• -To offer precise and useful details about factors affecting the growth of the Molecular Infectious Disease Testing market.
• -To provide a meticulous assessment of crucial business strategies used by leading companies operating in the Molecular Infectious Disease Testing market, which include research and development, collaborations, agreements, partnerships, acquisitions, mergers, new developments, and product launches.
Get (10-30%) Discount on Immediate Purchase 👉 https://www.usdanalytics.com/discount-request/32031
Major highlights from Table of Contents:
Molecular Infectious Disease Testing Market Study Coverage:
• It includes major manufacturers, emerging player's growth story, and major business segments of Molecular Infectious Disease Testing market, years considered, and research objectives. Additionally, segmentation on the basis of the type of product, application, and technology.
• Molecular Infectious Disease Testing Market Executive Summary: It gives a summary of overall studies, growth rate, available market, competitive landscape, market drivers, trends, and issues, and macroscopic indicators.
• Molecular Infectious Disease Testing Market Production by Region Molecular Infectious Disease Testing Market Profile of Manufacturers-players are studied on the basis of SWOT, their products, production, value, financials, and other vital factors.
Key Points Covered in Molecular Infectious Disease Testing Market Report:
• Molecular Infectious Disease Testing Overview, Definition and Classification Market drivers and barriers
• Molecular Infectious Disease Testing Market Competition by Manufacturers
• Molecular Infectious Disease Testing Capacity, Production, Revenue (Value) by Region (2025-2034)
• Molecular Infectious Disease Testing Supply (Production), Consumption, Export, Import by Region (2025-2034)
• Molecular Infectious Disease Testing Production, Revenue (Value), Price Trend by Type {Instruments, Reagents, Software}
• Molecular Infectious Disease Testing Market Analysis by Application {Diagnostics (PCR, NGS, Microarray)}
• Molecular Infectious Disease Testing Manufacturers Profiles/Analysis Molecular Infectious Disease Testing Manufacturing Cost Analysis, Industrial/Supply Chain Analysis, Sourcing Strategy and Downstream Buyers, Marketing
• Strategy by Key Manufacturers/Players, Connected Distributors/Traders Standardization, Regulatory and collaborative initiatives, Industry road map and value chain Market Effect Factors Analysis.
Browse Complete Summary and Table of Content 👉 https://www.usdanalytics.com/industry-reports/molecular-infectious-disease-testing-market
Key questions answered
• How feasible is Molecular Infectious Disease Testing market for long-term investment?
• What are influencing factors driving the demand for Molecular Infectious Disease Testing near future?
• What is the impact analysis of various factors in the Global Molecular Infectious Disease Testing market growth?
• What are the recent trends in the regional market and how successful they are?
Thanks for reading this article; you can also get individual chapter-wise sections or region-wise report versions like North America, LATAM, Europe, or Southeast Asia.
Contact Us:
Harry (Business Consultant)
USD Analytics Market
Phone: +1 213-510-3499
sales@usdanalytics.com
About Author:
USD Analytics Market is a leading information and analytics provider for customers across industries worldwide. Our high-quality research publications are connected market. Intelligence databases and consulting services support end-to-end support our customer research needs.
This release was published on openPR.
Permanent link to this press release:
Copy
Please set a link in the press area of your homepage to this press release on openPR. openPR disclaims liability for any content contained in this release.
You can edit or delete your press release Molecular Infectious Disease Testing Market Rewriting Long Term Growth Story here
News-ID: 3871484 • Views: …
More Releases from USD Analytics

Commercial Vehicle Telematics Market Is Booming So Rapidly | Gurtam, Teletrac Na …
The Global Commercial Vehicle Telematics Market Size is estimated at $7.1 Billion in 2025 and is forecast to register an annual growth rate (CAGR) of 13.6% to reach $22.4 Billion by 2034.
The latest study released on the Global Commercial Vehicle Telematics Market by USD Analytics Market evaluates market size, trend, and forecast to 2034. The Commercial Vehicle Telematics market study covers significant research data and proofs to be a handy…

Wind Turbine Operations and Maintenance Market Is Booming So Rapidly | Vestas, N …
The Global Wind Turbine Operations and Maintenance Market Size is estimated at $18.2 Billion in 2025 and is forecast to register an annual growth rate (CAGR) of 7.4% to reach $34.6 Billion by 2034.
The latest study released on the Global Wind Turbine Operations and Maintenance Market by USD Analytics Market evaluates market size, trend, and forecast to 2034. The Wind Turbine Operations and Maintenance market study covers significant research data…

Solar Trackers Market Is Booming So Rapidly | , Soltec, SunPower, Valmont
The Global Solar Trackers Market Size is estimated at $6.2 Billion in 2025 and is forecast to register an annual growth rate (CAGR) of 24.5% to reach $44.6 Billion by 2034.
The latest study released on the Global Solar Trackers Market by USD Analytics Market evaluates market size, trend, and forecast to 2034. The Solar Trackers market study covers significant research data and proofs to be a handy resource document for…

Aircraft Sensors Market Is Booming So Rapidly | Meggitt, Esterline, Indra
The Global Aircraft Sensors Market Size is estimated at $6.9 Billion in 2025 and is forecast to register an annual growth rate (CAGR) of 4.3% to reach $10.1 Billion by 2034.
The latest study released on the Global Aircraft Sensors Market by USD Analytics Market evaluates market size, trend, and forecast to 2034. The Aircraft Sensors market study covers significant research data and proofs to be a handy resource document for…
More Releases for Disease
Protheragen Announces Disease Model Development Services to Enhance Rare Disease …
Protheragen announced the release of its disease model development services provided to enhance rare disease research. With an increasing focus on rare diseases and the need for tailored research models, Protheragen is dedicated to providing cutting-edge solutions to support this important area of medical research.
Rare diseases, which affect a small percentage of the population, pose unique challenges for researchers due to their limited understanding and lack of available treatment options.…
Biopharmaceutical Fermentation Market 2022 | Growing Morbidity of Genetic Diseas …
According to Precision Business Insights (PBI), the latest report, the biopharmaceutical fermentation market is expected to be valued at USD 10,302.1 million in 2022, growing at a 4.7% CAGR from 2022 to 2028. The growing prevalence of chronic illness, cancer, cardiac diseases, infectious diseases, antibiotic resistance, autoimmune diseases, etc., globally causes the leaning toward biopharmaceutical products, which show promising results in the research studies. Moreover, new findings by the…
Global Inflammatory Bowel Disease (IBD) Market Key Players Analysis, Disease Ind …
Global Inflammatory Bowel Disease (IBD) Market, valued at USD 210.5 Billion in the year 2020 has been driven by factors such as the increasing prevalence of Ulcerative Colitis and Crohn’s Disease, advances in medical technology, government support for inflammatory bowel disease treatment research, and the ubiquity of anxiety and depression. Moreover, factors such as the irregular food habits, unhealthy lifestyle of people, increased level of pollution and increase in alcohol…
Moyamoya Disease Market - A Scientometric Assessment of Disease During 2018-23
Market Highlight:
Moyamoya disease (MMD) is a chronic, cerebrovascular disease characterized by progressive stenosis in the internal carotid artery and an abnormal vascular network at the base of the brain. The stroke is one of the significant symptoms of moyamoya disease, which further leads to paralysis of the face, arms, and legs, loss of speech, and temporary loss of neurologic function of body parts, visual disturbances, headaches, developmental delay, and…
Refsum Disease Industry An Overview of A New Disease - 2018
"Refsum Disease" is a genetic disorder which is inherited as an autosomal recessive trait. The condition is characterized by progressive loss of vision (retinitis pigmentosa), failure of muscle coordination (ataxia), degenerative nerve disease (peripheral neuropathy), and dry, rough, scaly skin (ichthyosis). The accumulation of fatty acid (phytanic acid) in blood plasma and tissues is the main cause of refsum disease. This occurs due to malfunction of the enzyme producing gene…
Chagas Disease (Infectious Disease) Pipeline Forecast Report, H1, 2017 [MRH]
Market Research Hub's Pharmaceutical and Healthcare latest pipeline guide Chagas Disease - Pipeline Review, H1 2017, provides comprehensive information on the therapeutics under development for Chagas Disease Market (Infectious Disease), complete with analysis by stage of development, drug target, mechanism of action (MoA), route of administration (RoA) and molecule type. The guide covers the descriptive pharmacological action of the therapeutics, its complete research and development history and latest news and…